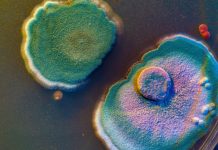
On the trail of microbes: Using bugs to tame urate and advance gout prevention

Innovation News Network brings you the latest research and innovation news from the fields of science, environment, energy, critical raw materials, technology, and electric vehicles.
UK and China advance scientific cooperation across critical industries
A delegation of senior UK figures is to visit China to explore opportunities for scientific cooperation that can benefit both countries.
UK to fast-track phase-out of animal testing in science
UK unveils £60m plan to phase out animal testing, accelerating the shift toward methods like organ-on-a-chip, AI, and 3D bioprinting.
On the trail of microbes: Using bugs to tame urate and advance gout prevention
EIC Bugs4Urate project pioneers living therapies and personalised nutrition to transform early gout prevention and metabolic health.
Invisible contaminants in the UK: Understanding the forever chemicals problem
Coventry University’s Dr Ivan Kourtchev discusses the growing concern over forever chemicals contamination in the UK
More range, less mass: The science of EV lightweighting
Ellie Gabel discusses how EV lightweighting – through smarter materials and AI-driven design – is boosting range and efficiency.
Saturn’s Enceladus moon may host life
Study reveals Saturn's Enceladus moon emits heat from both poles, supporting a stable subsurface ocean and potential habitability for life.
EU invests €358m in new LIFE Programme projects to drive climate action
EU’s LIFE Programme invests €358m in 132 projects advancing biodiversity, clean energy, and climate action across Europe.
EU’s €108bn plan accelerates low-carbon fuel for transport
The EU's Sustainable Transport Investment Plan will scale up the use of renewable and low-carbon fuel in aviation and waterborne transport.
Superconducting tapes: One big LEAP for fusion
Coherent’s LEAP series excimer lasers enable high-volume production of superconducting tapes essential for high-field fusion magnets.
Space dust could be the key to monitoring Arctic sea ice changes
University of Washington study reveals that tracking where cosmic dust has fallen can provide insight into Arctic sea ice coverage changes.